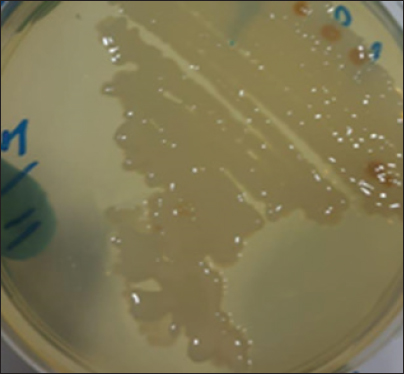
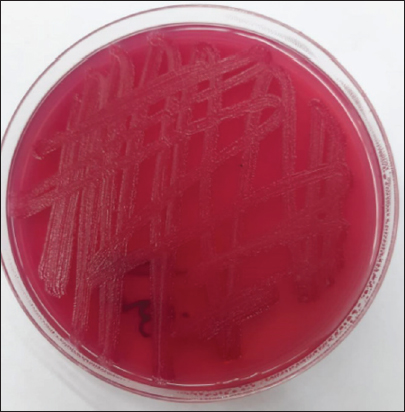

| Research Article | ||
Open Vet. J.. 2026; 16(2): 1259-1271
Open Veterinary Journal, (2026), Vol. 16(2): 1259-1271 Research Article Anticancer and immune effect of the extracted brown Raoultella planticola pigment on murine mammary adenocarcinoma (AMN3)Karrar Ali Mohammed Hasan Alsakini*, Asmaa Hamoody Abdullah and Hind H. Al-AmmiriMicrobiology Department, College of Veterinary Medicine, University of Baghdad, Baghdad, Iraq *Corresponding Author: Karrar Ali Mohammed Hasan Alsakini. Microbiology Department, College of Veterinary Medicine, University of Baghdad, Baghdad, Iraq. Email:karrar [at] covm.uobaghdad.edu.iq Submitted: 20/09/2025 Revised: 27/12/2025 Accepted: 07/01/2026 Published: 28/02/2026 © 2026 Open Veterinary Journal
AbstractBackground: Raoultella planticola is a developing pathogen that can infect both humans and animals. Raoultella spp. commonly colonize the gastrointestinal and upper respiratory systems. It usually causes pneumonia, bile tract infections, and bacteremia. Aim: In this study, the anticancer activity of an isolated brown pigment of a R. planticola isolate was tested in vitro. Methods: The laboratory examination included culturing in brain-heart infusion broth, conducting biochemical tests, using the automatic VITEK2 Compact for bacterial isolate identification, performing the 3-(4,5-dimethylthiazol-2-yl)-2,5-diphenyltetrazolium bromide assay to evaluate the cytotoxic effect on both the mammary cancer cell line (AMN3) and normal rat fibroblast (REF), and utilizing an enzyme-linked immunosorbent assay to measure cytokine levels. Results: Raoultella planticola was found in cow nasal swabs with respiratory problems. The extracted pigment had a significant cytotoxic effect (decreased cell viability) at doses of 2,067.5 μg/ml (p <0.0001 and 0.0001, respectively) and 1,033.5 μg/ml (p < 0.0001 and 0.003, respectively). However, the lowest dose (516.875 μg/ml, p > 0.43 and p > 0.18) could not inhibit the growth of malignant or healthy cells. The first and second highest pigment concentrations reduce Interleukin-1 beta and Tumor Necrosis Factor-alpha and increase Fas in the AMN3 cell supernatant (p < 0.05). In the AMN3 cell supernatant, the lowest concentration significantly increased IL-1β levels (p < 0.0472) and Fas levels (p < 0.0146), but did not affect TNF-α levels (p < 0.1274). Pigment concentrations at the first and second highest levels significantly reduced IL-1β and TNF-α levels in the REF cell supernatant (p < 0.05), whereas the lowest concentration did not. All pigment doses did not affect the Fas levels in the REF cell supernatant (p > 0.05). Conclusion: In a concentration-dependent manner, the extracted pigment may exert cytotoxic effects and impact cytokine secretion levels in cancerous and normal cell types. Keywords: Raoultella planticola, VITEK2, MTT assay, AMN3, Enzyme-linked immunosorbent assay. IntroductionEnvironmental "Klebsiella-like organisms" that used to be called Klebsiella terrigena, Klebsiella ornithinolytica, and Klebsiella planticola. The genus Raoultella was established in 2001 (Bollet and Rousselier, 2001). Klebsiella is polyphyletic and can be classified into two genera, with Raoultella regarded as a separate genus (Liu et al., 2020). The genome taxonomy database reports that Raoultella is a type of Klebsiella (Parks et al., 2022). The bacteria Klebsiella and Raoultella inhabit plants, water, and soil and may cause infections in humans and animals (Sękowska, 2017; Sękowska et al., 2018). Both genera are facultative anaerobic Gram-negative bacilli within the Enterobacteriaceae family that produce massive mucoid colonies on McConkey agar due to polysaccharide capsule synthesis. Consequently, both genera exhibit an analogous morphology, produce catalase, lack oxidase, ferment glucose, lactose, and sorbose, and reduce nitrates. Numerous metabolic characteristics differentiate species, including the indole test, growth at 10°C, histamine production, D-melezitose test, ornithine metabolism, pectate breakdown, pigment formation on gluconate-ferric citrate agar, and gentisate consumption in hydroxybenzoate as the sole carbon source. The microbiological diagnosis based on the analytical profile index uses these physiological and biochemical markers (Appel et al., 2021). Pigments are vibrant chemical substances that absorb light within the visible range (Sajid and Akbar, 2018). Collecting natural-origin pigments is a promising avenue for study and enhancement due to their superior attributes: safety, biodegradability, and eco-friendliness (Thaira et al., 2018; Pailliè-Jiménez et al., 2020; Elsayis et al., 2022). Bacterial pigments are much more desirable than plant or animal sources (DeBritto et al., 2020; Marey et al., 2024). Bacteria are considered the best source for pigment production because they have many benefits, such as a short and fast life cycle, easy culture maintenance, the ability to be used in large quantities for industrial purposes, the ability to adapt to environmental changes, the ability to grow on cheap and readily available media, easy extraction methods, and renewable resources that can lower production costs (Poddar et al., 2021). Microbial pigments are used to color food, plastic, textiles, paint, printing, and paper. They also have important therapeutic and pharmacological effects, such as being antimicrobial, antioxidant, anticancer, anti-inflammatory, immunomodulatory, antileishmanial, and antiviral (Debritto et al., 2020; Behera et al., 2021; Grewal et al., 2022; Huang et al., 2024; Marey et al., 2024). Algae, bacteria, fungi, yeasts, and protozoa make colorful pigments that are as good as artificial or inorganic coloring agents (Ramesh et al., 2019; Kim et al., 2022). Microorganisms produce a variety of colored byproducts, such as bacteriochlorophylls, carotenoids, flavins, indigoids, melanin, phenazine, astaxanthin, and β-carotene (Mussagy et al., 2019). Deinoxanthin, a carotenoid synthesized by the radioresistant Deinococcus radiodurans, exhibits antitumor properties. Free radicals are produced by normal cell function and can cause cancer. Deinoxanthin is better at eliminating Reactive Oxygen Species than carotenes like lycopene, β-carotene, and xanthophylls (Agarwal et al., 2023). In addition, bacterial pigments, such as prodigiosins (Ramya et al., 2025) and violacin (Dahlem et al., 2022), have been reported to have anticancer effects against several malignancies (Gajaraj and Nadumane, 2020). However, to the best of our knowledge, little information exists regarding the effects of the natural pigments of Raoultella planticola on cancer cells. In this study, the impact of pigments on the growth of the AMN3 and rat fibroblast (REF) cell lines and the production of cytokines was evaluated. Materials and MethodsCell lines and growth conditionsAll experiments followed established protocols, and the cell lines used in this study were obtained from the Cell Bank Unit, Experimental Therapy Department, at the Iraqi Center for Cancer and Medical Genetic Research, Mustansiriyah University, Baghdad, Iraq. A mammary cancer cell line (AMN3) and normal REF were cultured in MEM media supplemented with 10% fetal bovine serum (Gibco, USA), 100 μg/ml streptomycin, and 100 units/ml penicillin (Gibco), and incubated at 37°C in a 5% CO2 atmosphere (Al-Shammari et al., 2015). Isolation, identification, and biochemical characterization of bacteriaA total of 100 swabs were taken from cows suspected of pneumonia (respiratory manifestations), characterized by a temperature of 40°C, loss of appetite, coughing, depression, and nasal discharge ranging from mucoid to mucopurulent on both sides. Various farms in Baghdad Province provided samples collected between February and May 2025. After collecting the samples, they were placed in brain-heart infusion (B.H.I.) broth and sent to the laboratory for culturing and testing for biochemical factors. Colony morphology, staining reaction, and biochemical tests were used to identify the isolate (Quninn et al., 2004). The VITEK 2 system was also used to confirm the findings (Espinar et al., 2011). Observation of pigmentation on D-gluconate ferric citrate agar revealed a brown pigment, consistent with previous findings (Naemura and Seidler, 1978). Indole production was assessed by inoculating 2% peptone water, incubating at 35°C for 48 hours, and developing with Kovac’s reagent (Ewing, 1986). The fermentation of carbohydrates, specifically D-melezitose, L-sorbose, and dextrose, was evaluated using Enteric Fermentation Base with Andrade’s indicator (Westbrook et al., 2000). Extraction and purification of pigmentsTo begin extracting the pigment, reculture the bacteria on MacConkey agar using the streaking method. After incubation under aerobic conditions at 37°C for 24 hours, the bacterial isolate biomass was obtained from MacConkey agar. The entire harvested biomass was dissolved in 50 ml of 100% methanol (v/v) using a vortex mixer to ensure a uniform solution. Since the resulting pigment was not extracted from the centrifuged broth (7,000 rpm for 20 minutes at 4°C), it appeared to be present inside the cell (Padhan et al., 2021). Hence, the pigment was concluded to be intracellular. Thereafter, the resuspended pellet was lysed by ultrasonicating its dissolved cells for 30 minutes in a bath sonicator (Digital Ultrasonic Cleaner LC MU-2, Labman Scientific Instruments, Chennai, India). Following sonication, the solution combination was centrifuged at 7,000 rpm at room temperature for 15 minutes to separate the colorful supernatant from the colorless pellet. Thereafter, the pigment and methanol mixture was dried under controlled light and humidity conditions by placing the mixture inside the incubator at 37°C for 3 days. The extracted crude pigment was weighed after drying (Meddeb-Mouelhi et al., 2016; Sarkar et al., 2019; Padhan et al., 2021). Fourier transform infrared (FT-IR) spectroscopyThe FTIR spectrum has identified the functional groups. FT-IRspectroscopy analysis was performed on the purified pigments using a Perkin-Elmer FT-IR spectrometer, with the pigment samples scanned at wavenumbers ranging from 4,000 to 400 cm⁻¹, and the IR spectra were documented (El-Naggar and El-Ewasy, 2017; Bayram, 2022). Evaluation of anticancer activityThe effect of R. planticola pigment at 37°C was investigated using the MTT test in a study on AMN3 and REF cell viability. Cells were seeded overnight in 96-well plates at a density of 1 × 104 cells/well (Alsakini and Nalbantsoy, 2025; Çöven et al., 2024; Gokmen et al., 2025). The tested pigments were applied to the cells when a confluent monolayer was achieved. The pigment was prepared and solubilized with phosphate-buffered saline under sterile conditions. Cell viability was assessed after 72 hours of treatment at different doses (2,067.5, 1,033.5, 516.875 μg/ml) by removing the medium, adding 28 ml of an MTT (Sigma, USA) solution (stock concentration: 2 mg/ml), and incubating for 3 hours at 37°C. After removing the MTT solution, 130-μl dimethyl sulfoxide (Thermo Scientific, USA) was added to dissolve the crystals in the wells. The mixture was then incubated at 37°C for 15 minutes while continually shaking. The untreated cells were considered as the control group. The test was performed in triplicate. A microplate reader was used to measure the absorbency at 570 nm. The percentage of cytotoxicity, which represents the rate of cell growth inhibition, was calculated as follows: The inhibition rate=A- B/A*100 Where A is the control optical density and B is the sample optical density (Waheeb et al., 2020; Jabir et al., 2021). ELISAFollowing the manufacturer’s guidelines, ELISA Kits for IL-1β (Catalog No. E-EL-H0149), TNF-α (Catalog No. E-EL-H0109), and FAS (Catalog No. E-EL-H6196) from Elabscience, USA, were used to measure cytokine concentrations in cell culture supernatant samples. Statistical analysisThe data were analyzed using GraphPad Prism version 8 (GraphPad Software, Inc., La Jolla, CA) for the unpaired t-test. To determine statistical significance, the data are shown as mean ± SD of triplicate measurements. A significance level of p < 0.05 was considered significant. Ethical approvalThe College of Veterinary Medicine, University of Baghdad, granted the ethical approval for conducting this scientific work (dated 24.02.2025). ResultsIsolation and identification of R. planticola
Fig. 1. Morphological characteristics of R. planticola: Large, mucoid colonies on B.H.I. agar. The bacterial isolate was obtained from a cow with pneumonia. It was identified by incubating it under aerobic conditions at 37°C for 24 hours on B.H.I., MacConkey agar, and Blood agar. The colonies of R. planticola were large, mucoid colonies on B.H.I. agar-enriched medium (Fig. 1), while those on MacConkey agar were pink in color, lactose-fermented, and had a smooth, slimy texture (Fig. 2).
Fig. 2. Morphological characteristics of R. planticola: pink, lactose-fermenting, smooth, slimy-textured colonies on MacConkey agar.
Fig. 3. Morphological characteristics of R. planticola: large, mucoid, gray, with gamma-hemolytic characteristics on blood agar. Large, mucoid, gray colonies with gamma-hemolytic characteristics were observed on the blood agar (Fig. 3). Under a light microscope (Fig. 4), R. Planticola are short, straight, gram–negative rods arranged singly or in pairs, as described by Morse et al. (2013). The isolates were positive for catalase, negative for oxidase, negative for indole, and positive for urease (Macfaddin, 2000). The purity of the R. planticola isolate was confirmed by the VITEK 2+ system, which consists of 64 biochemical tests (Table 1). The Vitek2 system was used to confirm the identification of the R. planticola isolate (Espinar et al., 2011).
Fig. 4. Microscopical characteristics of R. planticola: short, straight, gram–negative rods arranged singly or in pairs under a light microscope (100×) Table 1. Biochemical results obtained using the VITEK® 2 system for R. planticola.
FTIR analysisThe FTIR spectrum determined the functional groups (Table 2 and Fig. 5). The alkene C=C stretching mode was responsible for the prominent peak observed at 3,390.86–3,282.84 cm−1. Crystallographic O-H stretch or alcohol molecules were likely present based on the peak characteristics at 2,926.01–2,856.58 cm−1. The broad peak at 1,647.21 cm−1 is credited to the extending mode of the N–H bend and C=C stretch (Amine, Alkene). Other crests found: The peak 1,406.11 cm−1 extending mode of the C–H bend (Alkane). The frequency 1,242.16 cm−1 extending mode of the C–O stretch (Alkyl aryl ether). The frequency 538.14 cm−1 extending mode of the C–Br stretch (Metal Oxide). Based on the peak value of the IR radiation region, the FTIR spectrum was used to determine the functional group of the active chemical in the pigment extracts. After determining the functional groups of the pigment extracted from R. platicola, the pigment (Fig. 6) was approximately 0.83 g/400 ml (Padhan et al., 2021).
Fig. 5. FTIR analysis of pigment extracts.
Fig. 6. Extraction (after centrifugation, A: Supernatant, B: Precipitant) and purification (C) of pigments. Table 2. FITR peak values and the function of the pigment extract; absorption spectra of the purified pigment.
Anticancer activity of the purified pigmentThe in vitro cytotoxicity of the microbial-extracted pigment was evaluated by inhibiting the proliferation of AMN-3 and REF cells (Fig. 7). This study demonstrated significant cytotoxic activity against the cell lines. The effect starts strong and weakens according to pigment concentration. The study found a significant toxic effect on AMN3 cell growth at concentrations of 2,067.5 and 1,033.5 μg/ml (p < 0.0001), but not at the third concentration of 516.875 μg/ml (p > 0.43). The mammary cancer cells were inhibited by 43.71%, 56.56%, and 82.62%, respectively (Fig. 7A and Table 3). The study revealed a notable toxic impact at concentrations of 2,067.5 μg/ml (p < 0.0001) and 1,033.5 μg/ml (p < 0.003), but not at 516.875 μg/ml (p > 0.18), on REF cell proliferation. The inhibition rates for normal REF were 48.01%, 77.63%, and 84.13%, respectively (Fig. 7B and Table 4).
Fig. 7. Cell viability (%) of microbial-extracted pigment against A) AMN3 and B) REF cell lines at 72 hours. * Statistically significant difference compared with the untreated (control) group for each cell line (p < 0.05), is: not significant. Table 3. Cytotoxic effect of extracted pigment on AMN3 proliferation (cell viability%) at various concentrations.
Table 4. Cytotoxic effect of extracted pigment on REF proliferation (cell viability%) at various concentrations.
Effect of the extracted pigment on cytokine levelsThe proinflammatory cytokines (IL-1β and TNF-α) and FAS/CD95 (factor related to apoptosis) were quantified in the culture supernatants after exposure to pigment (2,067.5, 1,033.75, and 516.875 μg/ml). As shown in Figure 7, the stimulation of the AMN3 cell line to pigment substantially inhibits the secretion of IL-1β and TNF-α cytokines. In this study, the secretion of IL-1β cytokine was significantly decreased in AMN3 cell lines stimulated with the first and second highest groups (concentrations) of microbial-extracted pigment: 2,067.5 μg/ml (p < 0.0003), and 1,033.75 μg/ml (p < 0.005), while the third lowest concentration 516.875 μg/ml (p < 0.0472) significantly increased IL-1β levels in the supernatant compared with the control group. According to the findings of this study, the secretion of TNF-α was also significantly inhibited in pigment-stimulated AMN3 cells: 2,067.5 μg/ml (p < 0.0052) and 1,033.75 μg/ml (p < 0.0043), while the lowest concentration (516.875 μg/ml) was not significantly different (p < 0.1274) compared with the control group. In contrast, the stimulation of the AMN3 cell line with pigment substantially enhanced the secretion of FAS/CD95 cytokine in all treated groups: 2,067.5 μg/ml (p < 0.0002), 1,033.75 μg/ml (p < 0.0004), and 516.875 μg/ml (p < 0.0146) compared to the control cells. As shown in Figure 9, the secretion of IL-1β cytokine from normal REF with first and second concentrations (groups) of microbial-extracted pigment was slightly significant compared with the control group: 2,067.5 μg/ml (p < 0.0267) and 1,033.75 μg/ml (p < 0.0348). Furthermore, the secretion level of TNF-α from the REF cell line was significantly affected by pigment treatment: 2,067.5 μg/ml (p < 0.0020) and 1,033.75 μg/ml (p < 0.0143) when compared with the control group. In contrast, the third concentration was not statistically significant for both IL-1β (p < 0.9546) and TNF-α (p < 0.2414) levels in the cell supernatant. The FAS/CD95 cytokine secretion was not statistically significant in the culture supernatants, regardless of cell stimulation with all concentrations of microbial-extracted pigment (p < 0.1894). DiscussionThis study aimed to determine how an R. planticola pigment affected cytokine production and proliferation of AMN3 and REF cell lines. To our knowledge,this study represents the first examination of the laboratory characteristics of R. planticola-associated respiratory manifestations in cattle in Baghdad province. The identification of Raoultella spp. has presented challenges since their discovery due to their phylogenetic similarity to the genus Klebsiella and their biochemical characteristics, including histamine utilization and D-melezitose decomposition, which are absent from standard commercial biochemical tests. Mass spectrometry and molecular biology techniques have facilitated the accurate identification of these bacteria at the genus and species levels (Sękowska et al., 2018). In this study, the isolate was diagnosed with routine work that included Gram staining, culture on selective, differential media, and biochemical tests specific to the bacterium. It was then confirmed using the VITEK2 system, which ensures a sufficient diagnosis of the bacterium. The molecular confirmation is essential. However, the diagnosis of bacteria by those experienced in the field allows them to dispense with genetic testing, especially since a single isolate has already been identified. This study employed morphological (Fig. 4) and biochemical tests for bacterial identification, consistent with the findings of a recent study (Dawood and Abdullah, 2025; Elarabi et al., 2023). The VITEK2 system is the most accurate automated method for identifying Raoultella spp. (Park et al., 2011). Specific biochemical tests could address the problems associated with PI systems. Experimental evidence indicates that Raoultella produces histamine, whereas Klebsiella does not. Multiple authors have proposed the incorporation of histamine, D-mannose, and growth at 10°C tests into the current systems to enhance the identification of Raoultella spp. (Hansen et al., 2004; Alves et al., 2006; Ponce-Alonso et al., 2016). In the present study, the VITEK2 analysis results demonstrated an accuracy consistent with expectations, reflecting an 87% probability that the isolated bacteria are R. planticola. The anticancer activity of several bacterial pigments is hypothesized to be mediated by many mechanisms, such as apoptosis, protein kinase activation, and cell cycle arrest (Li et al., 2018). The bright coloration of extremophilic bacteria prevents oxidative damage. Pigments preserve membrane integrity and stability (Agarwal et al., 2023) and exert cytotoxic action in pancreatic cancer cell lines (Celedón and Díaz, 2021). This study used R. planticola pigment, which has never been investigated for its anticancer activity. The pigment treatment in this study resulted in a notable reduction in the percentage of viable cancer cells (AMN3), which corresponded with elevated caspase activity and a reduced cell count relative to the control (untreated) group. The pigment treatment exhibited toxic effects on normal healthy cells (REF), analogous to its cytotoxic effects on cancer cells. The findings indicate that microbial-extracted pigment can inhibit cell line proliferation in a concentration-dependent manner (Fig. 7). The current investigation corroborated the findings of many studies, which identified a cytotoxic effect of different extracts on lung carcinoma (A549) (Kumar et al., 2021), colon carcinoma (Hct116) (Shahjahan et al., 2023), AMN3, and RFF cells (Merza et al., 2010; Zghair et al., 2010). The current study found that brown R. planticola pigment significantly reduced IL-1β in a dose-dependent manner, with lower concentrations showing an increase only in AMN3 cells and reduced TNF-α expression in AMN3 and REF cell supernatant compared to controls (Figs. 8 and 9). This result aligns with the literature that inflammation is key to carcinogenesis (Majidinia et al., 2017). The Fas/Fas Ligand or CD95L system regulates apoptosis and is associated with various immune system disorders and neoplasms (Lagunas‐Rangel, 2023). In this study, after 72 hours of exposure to bacterial pigment in AMN3 cell supernatant, Fas levels increased dramatically (Fig. 8), whereas there was no impact on Fas levels in REF cells (Fig. 9).
Fig. 8. The levels of cytokines (IL-1β, FAS, and TNF-α) in the supernatant of AMN3 cell lines at different concentrations of extracted pigment (2,067.5, 1,033.75, and 516.875 μg/ml) were determined.
Fig. 9. The levels of cytokines (IL-1β, FAS, and TNF-α) in the supernatant of REF cell lines at different concentrations of extracted pigment (2,067.5, 1,033.75, and 516.875 μg/ml) were determined. The balance between apoptosis and proliferation is crucial for cancer growth (Al-Ammiri et al., 2024; ElBakary et al., 2025). In this study, both malignant and normal cell lines showed decreased proliferation, whereas only cancerous cell lines exhibited increased FAS cytokine levels (the FAS cell surface death receptor is part of the tumor necrosis factor receptor family). When FAS is contacted by its ligand FASL, both apoptotic and non-apoptotic signals are initiated (Hu et al., 2025). FAS is initiated by its similar ligand, FASL, which is found on the plasma membrane. The reaction causes aggregation and shape changes. There are 2 types of FASL: transmembrane Membrane-bound Fas Ligand (mFASL) and soluble (sFASL). FASL is a glycoprotein found on the cell surface. sFASL mainly triggers non-apoptotic signaling pathways, whereas mFASL causes cell death (Risso et al., 2023). These findings were consistent with those of other studies that indicated that cancer cells exhibited reduced caspase-3 and increased BCL-2 levels, indicating a breakdown in the regulatory systems governing these processes. PPAR-γ, which promotes apoptosis and reduces cell proliferation, was similarly affected, suggesting that prodigiosin modulates both pathways in the tumor microenvironment (Hernandez-Quiles et al., 2021; Tan et al., 2021). It is crucial to acknowledge that research in this field is still in its infancy, necessitating further investigations to thoroughly understand the molecular pathways by which pigments influence cancer cells. This study states that the molecular identification of isolates is considered a limitation in the manuscript. These findings are not yet suitable for practical use in cancer treatment. Comprehensive preclinical and clinical trials are essential for evaluating safety and efficacy before developing any prospective pigment-based cancer therapeutics. Future research in this field may facilitate the efficient, large-scale, and cost-effective production of these natural pigments. ConclusionThe findings show that the pigment extracted from R. planticola can inhibit cancer cell growth in an experimental environment. The isolated pigment also appeared to decrease the levels of cytokines (IL-1β and TNF-α) in the supernatant of both normal healthy cells and the mammary cancer cell line. Additionally, the extract led to higher levels of FAS cytokine being released into the supernatant of cancer cells. However, more research is needed to determine how the pigment affects living organisms and interacts with other anticancer drugs. AcknowledgmentsNone. Conflict of interestNone declared. FundingNo funding. Authors' contributionsAll authors contributed significantly to the idea and design, data acquisition, or data analysis and interpretation. All authors consented to the submission to the current journal, provided final approval of the version for publication, and accepted accountability for all parts of the work. Data availabilityData sharing is not relevant to this study because no datasets were produced or examined in the current investigation. ReferencesAgarwal, H., Bajpai, S., Mishra, A., Kohli, I., Varma, A., Fouillaud, M., Dufossé, L. and Joshi, N.C. 2023. Bacterial pigments and their multifaceted roles in contemporary biotechnology and pharmacological applications. Microorganisms 11(3), 614; doi: 10.3390/microorganisms11030614 Al-Ammiri, H.H., Hasan Al-tai, T.H. and Mahdi, A.A.A. 2024. Validity of anti-nuclear antibodies, double strand DNA antibodies and other parameters in autoimmune hypoparathyroidism. Adv. Life Sci. 11(1), 72–76. Alsakini, K.A.M.H. and Nalbantsoy, A. 2025. Immunogenic potential of foot and mouth virus antigen O-146S adjuvanted with water-in-oil and water-in-oil-in-water emulsion in mice. Turk. J. Immunol. 13(2), 99–108; doi:10.36519/TJI.2025.671 Al-Shammari, A.M., Alshami, M.A., Umran, M.A., Almukhtar, A.A., Yaseen, N.Y., Raad, K. and Hussien, A.A. 2015. Establishment and characterization of a receptor-negative, hormone-nonresponsive breast cancer cell line from an Iraqi patient. Breast. Cancer. (Dove. Med. Press). 7, 223–230. Alves, M.S., Dias, R.C.D.S., De Castro, A.C.D., Riley, L.W. and Moreira, B.M. 2006. Identification of clinical isolates of indole-positive and indole-negative Klebsiella spp. J. Clin. Microbiol. 44(10), 3640–3646; doi:10.1128/JCM.00940-06 Appel, T.M., Quijano-Martínez, N., De La Cadena, E., Mojica, M.F. and Villegas, M.V. 2021. Microbiological and clinical aspects of Raoultella spp. Front. Public Health 9, 1–7; doi:10.3389/fpubh.2021.686789 Bayram, S.A. 2022. Comparative characterization study between fungal and bacterial eumelanin pigments. Indian. J. Microbiol. 62, 393–400; doi:10.1007/s12088-022-01012-1 Behera, H.T., Mojumdar, A., Nivedita, S. and Ray, L. 2021. Microbial pigments: secondary metabolites with multifaceted roles. In Microbial polymers. Eds., Vaishnav, A. and Choudhary, D.K. Springer, pp: 631–54. Celedón, R.S. and Díaz, L.B. 2021. Natural pigments of bacterial origin and their possible biomedical applications. Microorganisms 9(4), 1–12; doi:10.3390/microorganisms9040739 Çöven, F.O., Gür, S., Uyar, E., Alsakini, K.A.M.H., Karabey, F., Çöven, F., Çaliş, I. and Nalbantsoy, A. 2024. Assessment of in-vitro cytotoxicity and in-ovo virucidal antiviral efficacy of various plant extracts and bioactive molecules. Kafkas. Univ. Vet. Fak. Derg. 30(2), 171–178; doi:10.9775/kvfd.2023.30306 Dahlem, C., Chanda, S., Hemmer, J., Schymik, H.S., Kohlstedt, M., Wittmann, C. and Kiemer, A.K. 2022. Characterization of anti-cancer activities of violacein: actions on tumor cells and the tumor microenvironment. Front. Oncol. 12, 872223; doi:10.3389/fonc.2022.872223 Dawood, H. and Abdullah, A. 2025. Molecular detection of Klebseilla pneumoniae isolated from respiratory infected sheep and histopathological study in rabbits. Egypt. Vet. Sci. 56(6), 1143–1152; doi:10.21608/ejvs.2024.280375.1976 Debritto, S., Gajbar, T.D., Satapute, P., Sundaram, L., Lakshmikantha, R.Y., Jogaiah, S. and Ito, S.I. 2020. Isolation and characterization of nutrient dependent pyocyanin from Pseudomonas aeruginosa and its dye and agrochemical properties. Sci. Rep. 10(1), 1–12; doi:10.1038/s41598-020-58335-6 Bollet, D.C. and Rousselier, C.P. 2001. Drancourt. Int. J. Systematic. Evol. Micro. 2001, 925–932. Elarabi, N.I., Halema, A.A., Abdelhadi, A.A., Henawy, A.R., Samir, O. and Abdelhaleem, H.A.R. 2023. Draft genome of Raoultella planticola, a high lead resistance bacterium from industrial wastewater. AMB. Express. 13(1), 14; doi:10.1186/s13568-023-01519-w Elbakary, N.M., Anees, L.M., Said Shahat, A. and Mesalam, N.M. 2025. a promising natural red pigment “Prodigiosin” sensitizes colon cancer cells to ionizing radiation, induces apoptosis, and impedes MAPK/TNF-α/NLRP3 signaling pathway. Integr. Cancer. Therapies. 24, 15347354251342764; doi:10.1177/15347354251342764 El-Naggar, N.E.A. and El-Ewasy, S.M. 2017. Bioproduction, characterization, anticancer and antioxidant activities of extracellular melanin pigment produced by newly isolated microbial cell factories Streptomyces glaucescens NEAE-H. Sci. Rep. 7, 42129; doi:10.1038/srep42129 Elsayis, A., Hassan, S.W.M., Ghanem, K.M. and Khairy, H. 2022. Suggested sustainable medical and environmental uses of melanin pigment from halotolerant black yeast Hortaea werneckii AS1. Front. Microbiol. 13, S1–10; doi:10.3389/fmicb.2022.871394 Espinar, M.J., Rocha, R., Ribeiro, M., Gonçalves Rodrigues, A. and Pina-Vaz, C. 2011. Extended-spectrum β-lactamases of Escherichia coli and Klebsiella pneumoniae screened by the VITEK 2 system. J. Med. Microbiol. 60(6), 756–760; doi:10.1099/jmm.0.024075-0 Ewing. 1986. Edwards & Ewing identification of Enterobacteriaceae,4th ed. New York, NY: Elsevier Publishing Co. Gajaraj, B. and Nadumane, V. 2020. Caspase mediated cytotoxicity of a yellow pigment produced by Exiguobacterium alkaliphilum on human cancer cell lines. J. Pharm. Pharmacogn. Res. 8(1), 78–91; doi:10.56499/jppres19.685_8.1.78 Gokmen, B., Guler, C., Şanci, E., Demir, R., Karayildirim, C.K., Alsakini, K.A.M.H., Nalbantsoy, A., Guner, A., Ay, K., Karayildirim, T. and Yavasoglu, N.U.K. 2025. In silico and in vitro perspectives on the potential anticancer activity and toxicity of anticancer drug modified with carbohydrates containing novel triazole compounds. ChemistrySelect 10(21), 1–13; doi:10.1002/slct.202405927 Grewal, J., Woła., cewicz, M., Pyter, W., Joshi, N., Drewniak, L. and Pranaw, K. 2022. Colorful treasure from agro-industrial wastes: a sustainable chassis for microbial pigment production. Front. Microbiol. 13, 832918; doi:10.3389/fmicb.2022.832918 Hansen, D.S., Aucken, H.M., Abiola, T. and Podschun, R. 2004. Recommended test panel for differentiation of Klebsiella species on the basis of a trilateral interlaboratory evaluation of 18 biochemical tests. J. Clin. Microbiol. 42(8), 3665–3669; doi:10.1128/JCM.42.8.3665-3669.2004 Hernandez-Quiles, M., Broekema, M.F. and Kalkhoven, E. 2021. PPARgamma in metabolism, immunity, and cancer: unified and diverse mechanisms of action. Front. Endocrinol. 12, 1–17; doi:10.3389/fendo.2021.624112 Hu, L., Lu, J., Fan, H., Niu, C., Han, Y., Caiyin, Q., Wu, H. and Qiao, J. 2025. FAS mediates apoptosis, inflammation, and treatment of pathogen infection. Front. Cell. Infect. Microbiol. 15, 1561102; doi:10.3389/fcimb.2025.1561102 Huang, X., Gan, L., He, Z., Jiang, G. and He, T. 2024. Bacterial pigments as a promising alternative to synthetic colorants: from fundamentals to applications. J. Microbiol. Biotechnol. 34(11), 2153–2165; doi:10.4014/jmb.2404.04018 Jabir, M. S., Hussien, A. A., Sulaiman, G. M., Yaseen, N. Y., Dewir, Y. H., Alwahibi, M. S., Soliman, D. A. and Rizwana, H. 2021. Green synthesis of silver nanoparticles from Eriobotrya japonica extract: a promising approach against cancer cells proliferation, inflammation, allergic disorders and phagocytosis induction. Artif. Cells Nanomed. Biotechnol. 49(1), 48–60. doi: 10.1080/21691401.2020.1867152 Jawetz , E. and Melinck, J.A.E. 2010. Review of medical microbiology, 25th ed.). Appleton and Lange. Kim, H.J., Park, J.S. and Lee, J.H. 2022. Microbial pigments: biotechnological advances in medicine and industry. Curr. Pharm. Bio-Technol. 23(5), 315–328. Kumar, P., Chauhan, A., Kumar, M., Kuanr, B.K., Kundu, A., Solanki, R. and Kapur, M.K. 2021. In vitro and in silico anticancer potential analysis of Streptomyces sp. extract against human lung cancer cell line, A549. Biotech 11(6), 1–12; doi:10.1007/s13205-021-02812-w Lagunas‐Rangel, F.A. 2023. Fas (CD95)/FasL (CD178) system during ageing. Cell. Biol. Int. 47(8), 1295–1313; doi:10.1002/cbin.12032 Li, D., Liu, J., Wang, X., Kong, D., Du, W., Li, H., Hse, C.Y., Shupe, T., Zhou, D. and Zhao, K. 2018. Biological potential and mechanism of prodigiosin from Serratia marcescens subsp. Lawsoniana in human choriocarcinoma and prostate cancer cell lines. Int. J. Mol. Sci. 19(11), 3465; doi:10.3390/ijms19113465 Liu, L., Feng, Y., Wei, L., Qiao, F. and Zong, Z. 2020. Precise species identification and taxonomy update for the genus Kluyvera with reporting Kluyvera sichuanensis sp. nov. Front. Microbiol. 11, 579306; doi:10.3389/fmicb.2020.579306 MacFaddin, J.F. 2000. Biochemical Tests for Identification of Medical Bacteria. 3rd Edition, Lippincott Williams & Wilkins, Philadelphia. Morse, S.A., Brooks, G.F., Carrol, K.C., Mietzner, T.A., and Butel, J.S. 2013. Jawetz, Melnick & Adelberg's Medical Microbiology, 26th edition. Publisher: McGraw-Hill, New York. 15: p 229-241. Majidinia, M., Alizadeh, E., Yousefi, B., Akbarzadeh, M., Mihanfar, A., Rahmati-Yamchi, M., and Zarghami, N. 2017. Co-inhibition of Notch and NF-κB Signaling Pathway Decreases Proliferation through Downregulating IκB-α and Hes-1 Expression in Human Ovarian Cancer OVCAR-3 Cells. Drug Res., 67(1), 13–19. https://doi.org/10.1055/s-0042-115405 Marey, M.A., Abozahra, R., El-Nikhely, N.A., Kamal, M.F., Abdelhamid, S.M. and El-Kholy, M.A. 2024. Transforming microbial pigment into therapeutic revelation: extraction and characterization of pyocyanin from Pseudomonas aeruginosa and its therapeutic potential as an antibacterial and anticancer agent. Microbial Cell Factories 23(1), 1–21; doi:10.1186/s12934-024-02438-6 Meddeb-Mouelhi, F., Moisan, J.K., Bergeron, J., Daoust, B. and Beauregard, M. 2016. Structural characterization of a novel antioxidant pigment produced by a photochromogenic Microbacterium oxydans strain. Appl. Biochem. Biotechnol. 180(7), 1286–1300; doi:10.1007/s12010-016-2167-8 Merza, A.H., Al- Jeboori, K.Z. and Yaseen, N.Y. 2010. Cytotoxic effect of Datura stramonium extract on cancer cell lines. Iraqi J. Vet. Med. 34(1), 131–138; doi:10.30539/iraqijvm.v34i1.669 Mussagy, C.U., Winterburn, J., Santos-Ebinuma, V.C. and Pereira, J.F.B. 2019. Production and extraction of carotenoids produced by microorganisms. Appl. Microbiol. Biotechnol. 103, 1095–1114. Naemura, L.G. and Seidler, R.J. 1978. Significance of low-temperature growth associated with the fecal coliform response, indole production, and pectin liquefaction in Klebsiella. Appl. Environ. Microbiol. 35, 392–396. Padhan, B., Poddar, K., Sarkar, D. and Sarkar, A. 2021. Production, purification, and process optimization of intracellular pigment from novel psychrotolerant Paenibacillus sp. BPW19. Biotechnol. Rep. 29, 592; doi:10.1016/j.btre.2021.e00592 Pailliè-Jiménez, M.E., Stincone, P. and Brandelli, A. 2020. Natural pigments of microbial origin. Front. Sustain. Food. Syst. 4, 1–8; doi:10.3389/fsufs.2020.590439 Park, J.S., Hong, K.H., Lee, H.J., Choi, S.H., Song, S.H., Song, K.H., Kim H Bin., Park, K.U., Song, J. and Kim, E.C. 2011. Evaluation of three phenotypic identification systems for clinical isolates of Raoultella ornithinolytica. J. Med. Microbiol. 60(4), 492–499; doi:10.1099/jmm.0.020768-0 Parks , D.H., Chuvochina, M., Rinke, C., Mussig, A.J., Chaumeil, P. and Hugenholtz, P. 2022. GTDB : an ongoing census of bacterial and archaeal diversity through a phylogenetically consistent, rank normalized and complete genome-based taxonomy. Nucleic Acids Res. 50 (September 2021), 785–794. Poddar, K., Padhan, B., Sarkar, D. and Sarkar, A. 2021. Purification and optimization of pink pigment produced by newly isolated bacterial strain Enterobacter sp. PWN1. SN. Appl. Sci. 3, 105. Ponce-Alonso, M., Rodríguez-Rojas, L., Del Campo, R., Cantón, R. and Morosini, M.I. 2016. Comparison of different methods for identification of species of the genus Raoultella: report of 11 cases of Raoultella causing bacteraemia and literature review. Clin. Microbiol. Infect. 22(3), 252–257; doi:10.1016/j.cmi.2015.10.035 Quinn, P.J., Markey, B.K. K. Carter., Donnelly, W.J. and Leonard, F.C. 2004. Veterinary microbiology and microbial diseases. Blackwell Science Ltd., p: 327. Ramesh, C., Vinithkumar, N., Kirubagaran, R., Venil, C. and Dufossé, L. 2019. Multifaceted applications of microbial pigments: current knowledge, challenges and future directions for public health implications. Microorganisms 28(7), 186; doi:10.3390/microorganisms7070186 Ramya, S., Vijayakumar, S., Gomathi, T. and Vidhya, A. 2025. Prodigiosin pigment-producing Streptomyces diastaticus on semi-solid media and anticancer activity against colorectal (COLO-205) cell line. Microb. Pathogenesis. 204, 107579; doi:10.1016/j.micpath.2025.107579 Risso, V., Thomas, M., Guével, B., Lavigne, R., Com, E., Martin, S., Nivet, M., Pineau, C., Negroni, L., Lafont, É., Chevet, É., Eriksson, L. A., and Le Gallo, M. 2023. Metalloprotease-mediated cleavage of CD95 ligand. FEBS. J. 290, 3145–3164; doi: 10.1111/febs.16737 Sajid, S. and Akbar, N. 2018. Applications of fungal pigments in biotechnology. Pure Appl. Biol. 7(3), 922–930. Santos, A.L.D.C., Ferreira, A.C.A. and Figueiredo, J.R.D. 2022. Potential use of bacterial pigments as anticancer drugs and female reproductive toxicity: a review. Cienc. Anim. Bras. 23, 72911; doi:10.1590/1809-6891v23e-72911E Sarkar, A., Sarkar, D. and Poddar, K. 2019. Plant metabolites as new leads to drug discovery: approaches and challenges. In Medicinal plants: chemistry, pharmacology, and therapeutic applications. Eds., Swamy, M.K., Patra, J.K. and Rudramurthy, G.R. CRC Press, pp: 61–9. Sękowska, A., Mikucka, A. and Gospodarek-Komkowska, E. 2018. Identification of Raoultella spp.: comparison of three methods. Indian J. Med. Microbiol. 36(2), 197–200; doi:10.4103/ijmm.ijmm_17_99 Sękowska, A. 2017. Raoultella spp.—clinical significance, infections and susceptibility to antibiotics. Folia. Microbiol. (Praha). 62(3), 221–227; doi:10.1007/s12223-016-0490-7 Shahjahan, A., Sekar, S., Kasinathan, K. and ArulJothi, K.N. 2023. The cytotoxic and anti-tumor potential of methanolic extracts of Indian marine isolates in HCT116 colorectal cancer cells. Anticancer Agents Med. Chem. (Formerly. Curr. Med. Chem-Anti-Cancer. Agents). 23(17), 1974–1981. Tan, Y., Wang, M., Yang, K., Chi, T., Liao, Z. and Wei, P. 2021. PPAR-α modulators as current and potential cancer treatments. Front. Oncol. 11, 599995; doi:10.3389/fonc.2021.599995 Thaira, H., Raval, K., Manirethan, V. and Balakrishnan, R.M. 2018. Melanin nano-pigments for heavy metal remediation from water. Sep. Sci. Technol. 00(00), 1–10; doi:10.1080/01496395.2018.1443132 Waheeb, H.M., Sulaiman, G.M. and Jaber, M.S. Effect of hesperidin conjugated with golden nanoparticles on phygocytic activity: in vitro Study. In AIP Conference Proceedings, 2020 vol. 2213(1), pp 20–217. 2nd International Conference on Materials Engineering & Science (IConMEAS 2019), AIP Publishing, Baghdad, Iraq Westbrook, G.L., O'Hara, C.M., Roman, S.B. and Miller, J.M. 2000. Incidence and identification of Klebsiella planticola in clinical isolates with emphasis on newborns. J. Clin. Microbiol. 38, 1495–1497. Zghair, Z.R., Yaseen, N.Y. and Makkawi, T.A. 2010. The effect of crude extracts of Sonchus oleraceus on cancer cell growth (In vitro). Iraqi. J. Vet. Med. 34(2), 30–38; doi:10.30539/iraqijvm.v34i2.629 | ||
| How to Cite this Article |
| Pubmed Style Alsakini KAMH, Abdullah AH, Al-ammiri HH. Anticancer and immune effect of the extracted brown Raoultella planticola pigment on murine mammary adenocarcinoma (AMN3). Open Vet. J.. 2026; 16(2): 1259-1271. doi:10.5455/OVJ.2026.v16.i2.43 Web Style Alsakini KAMH, Abdullah AH, Al-ammiri HH. Anticancer and immune effect of the extracted brown Raoultella planticola pigment on murine mammary adenocarcinoma (AMN3). https://www.openveterinaryjournal.com/?mno=285274 [Access: February 27, 2026]. doi:10.5455/OVJ.2026.v16.i2.43 AMA (American Medical Association) Style Alsakini KAMH, Abdullah AH, Al-ammiri HH. Anticancer and immune effect of the extracted brown Raoultella planticola pigment on murine mammary adenocarcinoma (AMN3). Open Vet. J.. 2026; 16(2): 1259-1271. doi:10.5455/OVJ.2026.v16.i2.43 Vancouver/ICMJE Style Alsakini KAMH, Abdullah AH, Al-ammiri HH. Anticancer and immune effect of the extracted brown Raoultella planticola pigment on murine mammary adenocarcinoma (AMN3). Open Vet. J.. (2026), [cited February 27, 2026]; 16(2): 1259-1271. doi:10.5455/OVJ.2026.v16.i2.43 Harvard Style Alsakini, K. A. M. H., Abdullah, . A. H. & Al-ammiri, . H. H. (2026) Anticancer and immune effect of the extracted brown Raoultella planticola pigment on murine mammary adenocarcinoma (AMN3). Open Vet. J., 16 (2), 1259-1271. doi:10.5455/OVJ.2026.v16.i2.43 Turabian Style Alsakini, Karrar Ali Mohammed Hasan, Asmaa Hamoody Abdullah, and Hind H. Al-ammiri. 2026. Anticancer and immune effect of the extracted brown Raoultella planticola pigment on murine mammary adenocarcinoma (AMN3). Open Veterinary Journal, 16 (2), 1259-1271. doi:10.5455/OVJ.2026.v16.i2.43 Chicago Style Alsakini, Karrar Ali Mohammed Hasan, Asmaa Hamoody Abdullah, and Hind H. Al-ammiri. "Anticancer and immune effect of the extracted brown Raoultella planticola pigment on murine mammary adenocarcinoma (AMN3)." Open Veterinary Journal 16 (2026), 1259-1271. doi:10.5455/OVJ.2026.v16.i2.43 MLA (The Modern Language Association) Style Alsakini, Karrar Ali Mohammed Hasan, Asmaa Hamoody Abdullah, and Hind H. Al-ammiri. "Anticancer and immune effect of the extracted brown Raoultella planticola pigment on murine mammary adenocarcinoma (AMN3)." Open Veterinary Journal 16.2 (2026), 1259-1271. Print. doi:10.5455/OVJ.2026.v16.i2.43 APA (American Psychological Association) Style Alsakini, K. A. M. H., Abdullah, . A. H. & Al-ammiri, . H. H. (2026) Anticancer and immune effect of the extracted brown Raoultella planticola pigment on murine mammary adenocarcinoma (AMN3). Open Veterinary Journal, 16 (2), 1259-1271. doi:10.5455/OVJ.2026.v16.i2.43 |